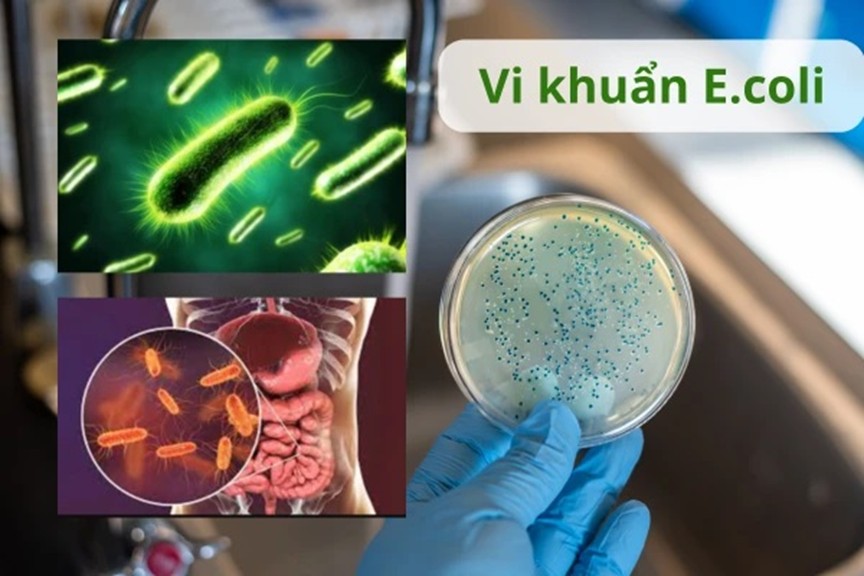

Hãy cùng khám phá những gì đang ẩn chứa trong nước uống hàng ngày và cách chúng ta loại bỏ tạp chất nước hiệu quả nhé!

Các chất độc hại tồn dư có thể có trong nước nhiễm bẩn
1. Những “Kẻ Vô Hình” Trong Nước: Ai Cũng Cần Biết
Nước máy hay nước giếng khoan mà bạn dùng trong sinh hoạt hàng ngày có thể chứa nhiều chất độc hại trong nước mà mắt thường không thể nhìn thấy, nhưng ảnh hưởng lại rất thật:
• Chì (Pb)
Một trong những kim loại nặng nguy hiểm nhất. Chì tích tụ trong cơ thể lâu dần ảnh hưởng nghiêm trọng tới hệ thần kinh, đặc biệt là trẻ em với sự phát triển não bộ chưa hoàn thiện. Nhiều nghiên cứu chỉ ra việc tiếp xúc chì lâu dài có thể dẫn tới chậm phát triển, rối loạn học tập.
• Asen (As)
Không gây triệu chứng ngay tức thì nhưng asen là chất độc mạnh với khả năng gây ung thư, rối loạn nội tiết và các vấn đề về tim mạch khi tích tụ lâu dài.

Asen (As)
• Clo (Cl)
Được dùng để sát khuẩn nước nhưng nếu dư thừa lại gây kích ứng da, mắt, ảnh hưởng tới hệ hô hấp và gây ra những hợp chất có thể gây hại. Clo đôi khi cũng tạo ra mùi khó chịu khiến nước mất vị tự nhiên.
• Vi khuẩn và vi sinh vật (E.Coli, Coliforms)
Đây là những tác nhân gây bệnh đường tiêu hóa, nhiễm trùng nghiêm trọng nếu nước không được xử lý đúng cách. Chỉ cần một lượng nhỏ thôi cũng đủ gây đau bụng, tiêu chảy…
Vi khuẩn E.coli

Vi khuẩn Coliforms
• Kim loại nặng khác (Hg – thủy ngân, Cd – cadmium)
Gây ảnh hưởng xấu tới chức năng thận, tổn thương gan và hệ thần kinh. Các kim loại này rất khó phân hủy trong tự nhiên và dễ tích tụ trong cơ thể theo thời gian.
• Nitrate và nitrit
Các hợp chất nitơ này thường đến từ phân bón, nước thải, hoặc sự phân hủy các chất hữu cơ. Với trẻ nhỏ, chúng có thể gây tình trạng thiếu oxy trong máu (methemoglobinemia) – một tình trạng cực kỳ nguy hiểm.

Nitrate
2. Chất Độc Hại Ảnh Hưởng Như Thế Nào Đến Sức Khỏe?
Những chất độc hại trong nước không chỉ là những con số trừu tượng trên bảng kiểm nghiệm – chúng có ảnh hưởng rõ rệt tới cơ thể:
- Gây bệnh mãn tính: Nhiễm kim loại nặng kéo dài có thể dẫn tới ung thư, tổn thương gan, thận và các bệnh tim mạch.
- Ảnh hưởng hệ thần kinh: Chì và thủy ngân cực kỳ độc đối với não bộ, đặc biệt với trẻ em.
- Rối loạn nội tiết và hệ miễn dịch: Một số chất hóa học có thể gây biến đổi hormone, làm suy giảm hệ miễn dịch.
- Nhiễm khuẩn cấp tính: Vi sinh vật gây bệnh trong nước chưa qua xử lý có thể gây tiêu chảy, ngộ độc, nhiễm trùng.
Vì vậy, xử lý nước an toàn không phải là một lựa chọn “hữu ích”, mà là bước sống còn để bảo vệ sức khỏe cho mỗi thành viên trong gia đình.
3. Làm Sao Để Có “Nước Sinh Hoạt Sạch”?
Để biến nguồn nước chứa nhiều nguy cơ thành nước sinh hoạt sạch, ta cần áp dụng nhiều phương pháp và thiết bị xử lý khác nhau. Tùy thuộc vào chất ô nhiễm cụ thể, mỗi cách xử lý sẽ mang đến hiệu quả khác nhau.
• Lọc cơ học (UF, RO)
Công nghệ màng lọc UF (Ultra Filtration) và RO (Reverse Osmosis) có khả năng loại bỏ tạp chất nước như vi khuẩn, virus, kim loại nặng, nitrat và các hạt lơ lửng hiệu quả. Các hệ thống này thường là bước đầu tiên để xử lý nước an toàn trong hộ gia đình.
• Than hoạt tính
Than hoạt tính rất hiệu quả để hấp thụ clo dư, các hợp chất hữu cơ và mùi vị khó chịu, giúp nước trở nên tinh khiết hơn và dễ uống hơn.
• Sục khí, oxy hóa và hấp phụ
Các phương pháp tiên tiến như sục khí, sử dụng than hoạt tính, chất hấp phụ và phản ứng oxi hóa giúp loại bỏ các hợp chất khó tan và độc hại.
• Đun sôi nước
Đây là phương pháp đơn giản nhất để tiêu diệt vi khuẩn và vi sinh vật, nhưng không loại bỏ được các kim loại nặng hoặc hóa chất.
• Công nghệ tiên tiến từ Mizuchan
Mizuchan cung cấp giải pháp tích hợp các công nghệ lọc tiên tiến để xử lý nước từ nguồn đến đầu ra – giúp nước không chỉ an toàn mà còn bảo vệ sức khỏe lâu dài cho người dùng. Hệ thống lọc của Mizuchan có thể thích hợp với nhiều nguồn nước khác nhau, bao gồm nước giếng khoan, nước máy hoặc các nguồn nước công nghiệp được chuyển thành nước sinh hoạt sạch.

Máy lọc nước uống UF giữ khoáng - Mizuchan MIZ-UF01
4. Lựa Chọn Hệ Thống Xử Lý Nước An Toàn
Khi lựa chọn hệ thống lọc nước, hãy chú ý tới những yếu tố sau:
- Khả năng loại bỏ tạp chất nước như kim loại nặng, vi khuẩn, virus và hợp chất hóa học.
- Độ bền và hiệu quả lâu dài để giảm chi phí bảo trì.
- Ứng dụng phù hợp cho từng loại nguồn nước (nước máy, giếng khoan, nước ô nhiễm phèn mặn…).
- Dịch vụ bảo trì và hậu mãi hỗ trợ người dùng sau khi lắp đặt.
Mizuchan không chỉ cung cấp sản phẩm mà còn tư vấn giải pháp phù hợp với nhu cầu thực tế của mỗi gia đình và doanh nghiệp, đảm bảo bạn xử lý nước an toàn mà vẫn duy trì chất lượng nước tối ưu.
Tham khảo ngay: Máy lọc nước UF giữ khoáng Mizuchan MIZ-UF01
5. Nước “Sạch” Không Chỉ Là Trong Trẻo
Nguồn nước bạn sử dụng hàng ngày có thể chứa rất nhiều chất độc hại tồn dư trong nước – từ kim loại nặng tới vi sinh vật và các hợp chất nitrat, nitrit. Những nguy cơ đó có thể gây ra hậu quả nghiêm trọng nếu không được nhận biết và xử lý đúng cách. Việc xử lý nước an toàn là bước thiết yếu để bảo vệ sức khỏe cho chính bạn và những người thân yêu.
Hãy liên hệ Mizuchan để có thêm thông tin về lọc và xử lý nước:
• Website: www.mizuchan.org
• Email: [email protected]
• Hotline: 0812896111 – 0812136111 - MIZUCHAN CO., LTD

























